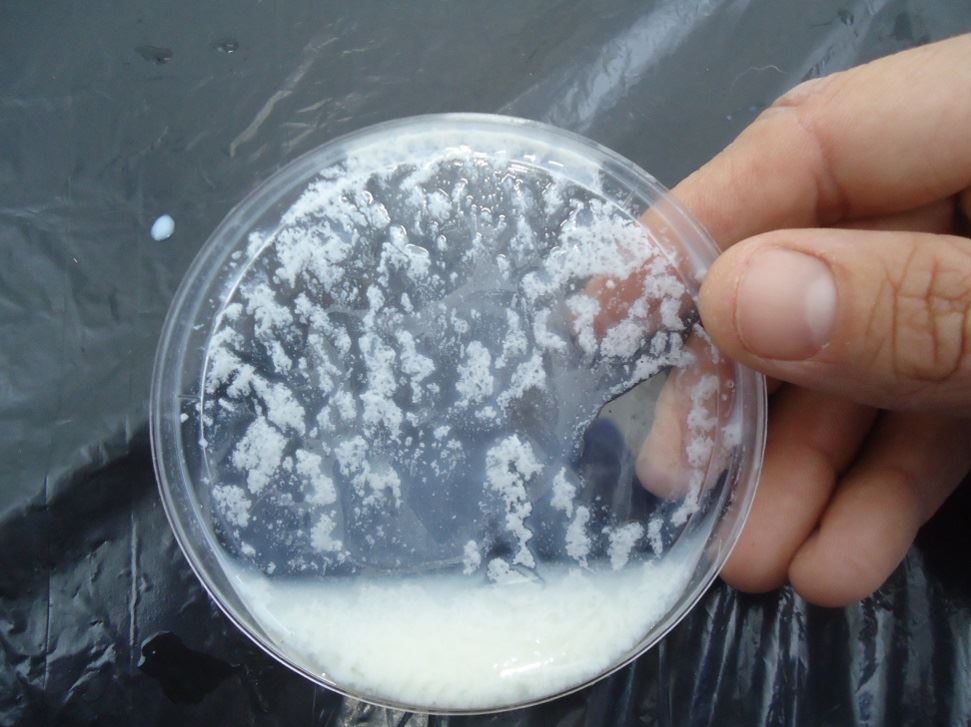

Quando o assunto é estabilidade do leite, temos em vista um aspecto de grande importância, uma vez que todos os produtos lácteos passam por algum tipo de processamento. Diversos fatores influenciam na qualidade do leite, que por sua vez tem grande influência no valor nutricional e na segurança dos derivados produzidos. Dentre eles, podemos citar:
• genéticos: espécie, raça
• intrínsecos: idade, estágio da lactação, número de lactações
• nutricionais: tipo de alimento que recebe, alimentos adequados a exigência do animal
• ambientais: estresse, manejo, condições ambientais no geral
• extrínsecos: sanidade, contaminação bacteriana
Como um todo, a qualidade do leite é o equilíbrio do sistema de produção, e quando encontra-se em desequilíbrio, temos como resultado o LINA. A principal alteração que resulta nesta situação é a perda da estabilidade da caseína ao teste do álcool (alizarol), levando a precipitação positiva, sem haver acidez elevada.
⇨ Análise do alizarol: consiste em misturar volumes iguais de leite e de alizarol – deve ser feita antes da coleta, o leite deve ser agitado e então realizado o teste do álcool, na concentração mínima de 72%, devendo apresentar-se estável (é considerado estável o leite que não apresenta precipitação). Além disso, deve-se observar a coloração da mistura, sendo a cor “vermelho tijolo” considerada em situações de estabilidade.
• Em casos positivos, serão vistos grumos e coloração amarelada ou mais fraca que o vermelho tijolo. Logo, nessas ocasiões, o leite não é coletado pelo transportador – o que traz grandes prejuízos para o produtor, pois não é aproveitado de nenhuma forma.
Leia também: Fatores que influenciam a composição do leite
Primeiramente, quando resultados positivos são encontrados, é importante saber diferenciar se o caso em si é realmente LINA ou leite ácido – o leite ácido é basicamente a degradação da lactose pela ação bacteriana, resultando na transformação da mesma em ácido lático e elevando a acidez do leite; Nesses casos, para solucionar o problema, o aconselhável é adotar a obtenção higiênica do leite e resfriamento adequado (4°C).
Algumas condições devem ser consideradas na realização dos testes, para que não haja interpretações equivocadas:
• correta agitação do leite
• não realizar o teste no leite recém-ordenhado (o leite recém-ordenhado possui CO2 natural, o que pode resultar em falsos positivos)
• as amostras de leite coletadas devem ser armazenadas na geladeira com frascos destampados, para assim volatizar o CO2, e analisadas após 4 a 6 horas pós-ordenha
• concentração do álcool utilizado no teste: quanto maior a concentração, maior a ação desidratante sobre a caseína do leite = maior ocorrência de LINA)
• temperatura do teste: o recomendado é que o teste seja feito com leite refrigerado
• pH do álcool: os extremos (baixo e alto) aumentam a frequência de amostras positivas
Causas do LINA
• restrição alimentar: baixa disponibilidade de matéria seca (MS) ou restrição no tempo de pastejo
• tempo de lactação: maior incidência no início da lactação (baixa estabilidade do colostro)
• estresse térmico: aumento da taxa respiratória > alcalose respiratória > acidose metabólica > redução da estabilidade
Tratamento e prevenção
Em contrapartida, imprevistos na propriedade podem facilmente resultar nos casos de LINA. Situações como falta de ração, mudanças abruptas na dieta, calor excessivo, entre milhares outros levam a restrição no uso deste leite. Por outro lado, ajustes na dieta de acordo com as exigências nutricionais, visando a necessidade de cada animal em determinado período, são ótimos caminhos para a prevenção. Além disso, um adequado controle leiteiro é de grande ajuda na gestão do mesmo.
Considerações Finais
Como resultado, o planejamento e entendimento dos fatores que afetam a qualidade do leite são fundamentais para obter sucesso na produção, de forma a garantir eficiência na atividade. Dessa forma, o ajuste de dietas buscando atender as exigências nutricionais dos animais é uma grande aliada na melhoria da estabilidade do leite.

Respostas de 2
Muito bom